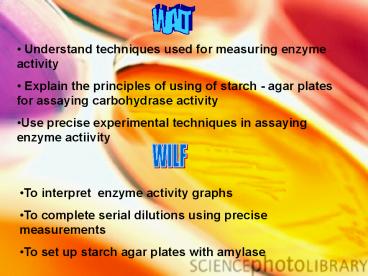

WALT PowerPoint PPT Presentation
1 / 10
Title: WALT
1
WALT
- Understand techniques used for measuring enzyme
activity - Explain the principles of using of starch - agar
plates for assaying carbohydrase activity - Use precise experimental techniques in assaying
enzyme actiivity
WILF
- To interpret enzyme activity graphs
- To complete serial dilutions using precise
measurements - To set up starch agar plates with amylase
2
Here are some answers to enzyme related
questions Can you write a question for each?
Answer - Lock and key, induced fit
Answer - Ionic, disulphide (bridges) and
hydrogen bonds
Answer - Increased (kinetic) energy
enzyme/substrate moves faster, including
collisions
Answer - Denatured
Answer - Amylase
3
Enzyme Kinetics - measuring the rate of enzyme
reactions. To measure an enzyme catalysed
reaction you need a signal to measure that shows
the progress of the reaction. The signal should
change with either substrate or product
concentration, and it should preferably be
something that can be measured continuously.
Can you think of possible signals? Typical
signals include colour changes, pH changes, mass
changes, gas production, volume changes or
turbidity changes. If the reaction has none of
these properties, it can sometimes be linked to a
second reaction, which does generate one of these
changes.
4
One useful method is to dissolve the substrate in
agar in an agar plate. If a source of enzyme is
placed in the agar plate, the enzyme will diffuse
out through the agar, turning the substrate into
product as it goes.
There must be a way to distinguish the substrate
from the product, and the reaction will then show
up as a ring around the enzyme source. What
signal could be used to show the digestion of
starch?
5
The higher the concentration of enzyme, the
higher the diffusion gradient, so the faster the
enzyme diffuses through the agar, so the larger
the ring in a given time.
The diameter of the ring is therefore
proportional to the enzyme concentration. This
can be done for many enzymes, e.g. a protein agar
plate can be used for a protease enzyme, or a
starch agar plate can be used for the enzyme
amylase.
6
Starch Agar Plate
You are now going to set up an agar plate to
assay the activity of amylase
7
(a) Name the part of the enzyme labelled
D. ...............................................
..................................................
..................................................
... (1 mark) (b) Explain how substrate C is
broken down by the enzyme. .......................
..................................................
............................... ..................
..................................................
.................................... .............
..................................................
.........................................
Active site 1
Substrate enters active site Complimentary
shapes / Lock and Key (Binding) to form
enzyme-substrate complex Lowering of activation
energy Conformational / shape change Breaking
of bonds in substrate Products no longer fit
active site and so are released
8
(c) Molecules A and B inhibit the enzyme in
different ways. Explain how each molecule
inhibits the enzyme. Molecule A
..................................................
..................................................
.... .............................................
..................................................
......... ........................................
..................................................
............. ....................................
..................................................
................. Molecule B .....................
..................................................
................................ .................
..................................................
.................................... .............
..................................................
........................................ .........
..................................................
............................................. (4
marks)
Molecule A binds at site away from active site /
allosteric site Causes enzyme / active site to
change shape
Prevents substrate from entering / no
enzyme-substrate complex formed / active site
blocked
9
(i) Describe how a saprophytic fungus obtains its
food. ............................................
..................................................
.............................................. ...
..................................................
.................................................
(2 marks)
Secretes enzymes (for extra-cellular
digestion) Absorbs products
(ii) What conclusion can be drawn from the
results? .........................................
..................................................
...... ...........................................
..................................................
... (1 mark) (iii) Use an appropriate method to
estimate the maximum rate of reaction that was
observed in this investigation. Show your
working. Maximum rate of reaction
..................................................
..................................................
..................................................
..................................................
..................................................
..................................................
..................................................
..................................................
..................................................
.................................. (2 marks)
ii) Optimum pH is 7 / neutral / between 6 and 8 /
between 7 and 8
Max rate Distance 11 60
Time 4
2.75 mm / hour, 0.046mm/min, 4.6 x 10-3 mm/min 1
mm/ 21.8 mins, 23.76mm2/hour
10
(No Transcript)